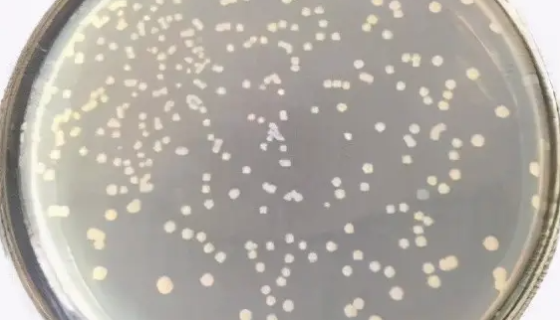
杀鲑气单胞菌——用于有机化工污水的处理
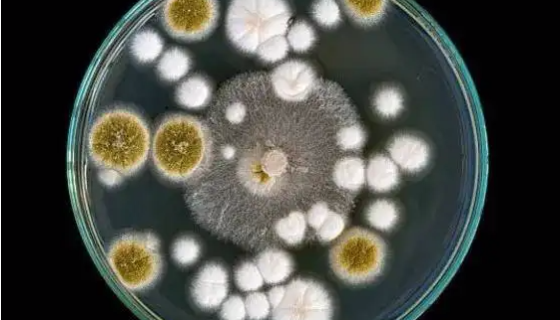
食腺嘌呤芽生葡萄孢酵母冻干管打管说明书！
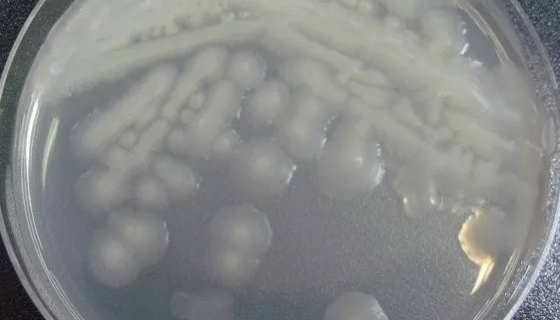
粪产碱菌粪亚种的培养方法与注意事项！

L-929 小鼠成纤维细胞的处理方法与培养步骤!
小鼠成纤维细胞分离自小鼠皮肤组织的贴壁细胞,成纤维细胞是疏松...

假坚强芽孢杆菌——用于生产碱性弹性蛋白酶
假坚强芽孢杆菌是Bacillus属的微生物,原产地为中国。杆...

HFLS-RA 类风湿关节炎成纤维样滑膜细胞
类风湿关节炎成纤维样滑膜细胞,仅用于科学研究或者工业应用等非...

国标大肠菌群检测方法的对比之MPN法和平板计数法!
大肠菌群作为一群在一定条件下能发酵乳糖、产酸产气的需氧或兼性...

JAR人胎盘绒毛癌细胞的培养操作步骤及应用!
JAR人胎盘绒毛癌细胞源自一位男性胎儿胎盘滋养层肿瘤的上皮细...
杀鲑气单胞菌——用于有机化工污水的处理
杀鲑气单胞菌,短杆状,G-,单极毛运动,无荚膜;兼性厌氧,化...
食腺嘌呤芽生葡萄孢酵母冻干管打管说明书!
食腺嘌呤芽生葡萄孢酵母是Blastobotrys属的微生物,...
粪产碱菌粪亚种的培养方法与注意事项!
粪产碱菌粪亚种是Alcaligenes属的微生物,原产地为中...

SDBMSCSD大鼠骨髓间充质干细胞的培养操作步骤!
大鼠骨髓间充质干细胞是骨髓基质干细胞,是人们在哺乳动物的骨髓...